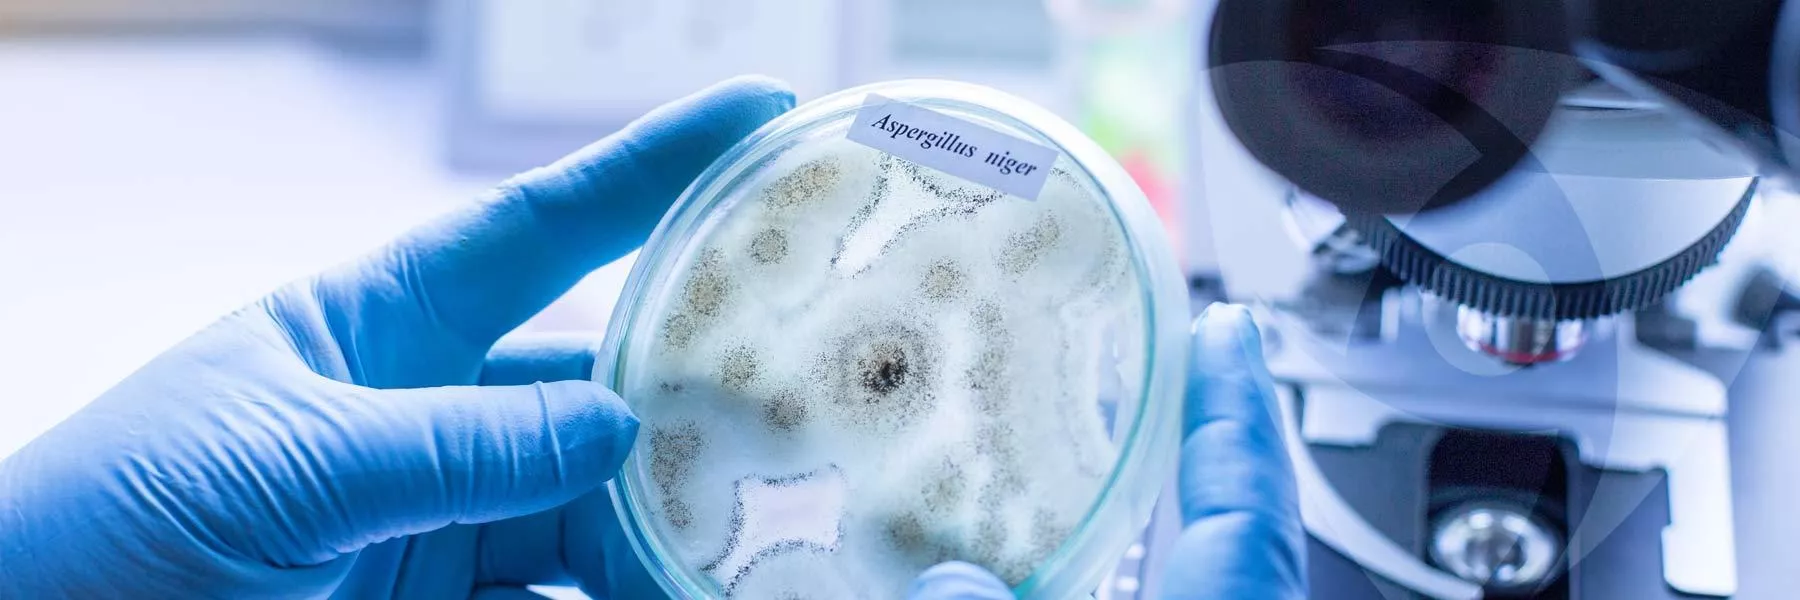

What are Microban ZPTech® technologies?
ZPTech zinc technology is a broad-spectrum antimicrobial with proven efficacy against the growth of bacteria, mold, and mildew. ZPTech has multiple modes of action, making it harder for microbes to become resistant to its effects.
Products are delivered in a liquid dispersion form that incorporates the antimicrobial power of zinc directly within textile fibers and foams, making it a very durable antimicrobial. ZPTech dispersions are offered in both aqueous and non-aqueous carriers; non-aqueous dispersions are ideal for foam manufacturing processes that cannot tolerate significant quantities of water.
What are the benefits of ZPTech zinc antimicrobial technologies?
ZPTech presents numerous benefits, including broad-spectrum performance, low solubility, and enhanced thermal stability.
- Low solubility: ZPTech offers a low solubility (8 ppm), making it a very durable antimicrobial
- Durable: Durability testing shows that polymers soaked for 2000 hours at 70°C in a detergent bath containing 3000 ppm ZPTech remained 99.99% effective in preventing the growth of Klebsiella pneumoniae, a Gram-negative bacteria associated with hospital-acquired infections.
- Thermally stable: The thermal stability of ZPTech makes it suitable for use in a variety of manufacturing applications and materials used in moist, humid environments, such as cleaning sponges, sealants, cement, polyolefin film liners, commercial cleaning trolleys, and coatings. ZPTech’s high thermal stability – up to 235°C – makes it suitable for use in various textile dyeing and pad finishing applications, including those that must be applied at high heat.
- Works 24/7: ZPTech is constantly active on the surface of treated products. It is incorporated throughout the material during manufacturing, ensuring it remains effective even if an object is nicked, scratched or abraded in use.
- Safe to use: ZPTech encapsulates zinc pyrithione in customized carriers, making it safe to handle while not disrupting current manufacturing processes.
- Aesthetics and function: ZPTech is tested with each product to ensure all product attributes – including wicking, moisture management, color fastness and hand – are protected.
- Stewardship: We utilize low- and no-VOC products, non-formaldehyde formulations and recycled materials to ensure our products comply with applicable environmental regulations, such as Restriction of Hazardous Substances (RoHS) and REACH. ZPTech is Oeko-Tex® certified.
- Textile compatibility: ZPTech effectively inhibits bacterial growth on synthetic fabrics by up to 99.9% and prevents mold growth for up to 50 home launderings, keeping garments and other soft goods fresher and cleaner between washes and preventing permanent odor build-up.
How do zinc technologies work?
When mold and mildew come in contact with product surfaces, ZPTech technology penetrates the microbe's cell wall and disrupts key cell functions so that the microbe cannot function, grow or reproduce.
Microban offers various zinc antifungal technologies built into products such as artificial turf, caulks and sealants, paints and coatings, and cement. These targeted technologies are time-tested and proven to offer superior mold prevention on surfaces.
How do you validate antifungal efficacy?
Microban's fungal testing lab performs various industry-standard test methods to validate antifungal efficacy. Samples can be evaluated utilizing nutrient challenge protocols or in the fungal chamber, which simulates environmental conditions using the AATCC Test Method 30, Part III.

Common mold growing on untreated tile grout

Same material treated with Microban ZPTech zinc technology
All products engineered with Microban ZPTech technology undergo extensive testing in our microbiology and chemical analysis labs. In addition, Microban technology has been proven effective in over 20,000 tests at over 27 independent laboratories worldwide.
Using industry-standard test methods, the samples pictured demonstrate the effectiveness of ZPTech technology against mold that can cause stains, odors, and product deterioration.